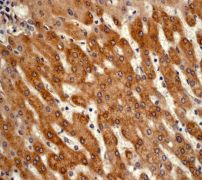

> Antigen, Antibodies, ELISA, Western Blot > Primary Antibody > Monoclonal Antibodies > UBC-1 AntibodyBrand |
Leading Biology | Catalog Number |
APR13898G |
Product Type |
Monoclonal Antibodies | Field of Research |
|
Product Overview |
We constantly strive to ensure we provide our customers with the best antibodies. As a result of this work we offer this antibody in purified format.
We are in the process of updating our datasheets. If you have any questions regarding this update, please feel free to contact our technical support team.
This product is a high quality UBC-1 antibody.
|
||
Molecular Weight |
22407 Da
|
||
Cellular Localization |
Antigen Cellular Localization:
Cytoplasm.
|
||
Host |
Rabbit
|
||
Species Reactivity |
Human, Mouse, Rat
|
||
Target |
A synthetic peptide corresponding to residues of human UBC1 was used as an immunogen.
|
||
Clone |
EP1145Y
|
||
Symbol |
HIP2, LIG
|
||
GeneID |
|||
UniProt ID |
|||
Function |
Accepts ubiquitin from the E1 complex and catalyzes its covalent attachment to other proteins. In vitro, in the presence or in the absence of BRCA1-BARD1 E3 ubiquitin-protein ligase complex, catalyzes the synthesis of 'Lys-48'-linked polyubiquitin chains. Does not transfer ubiquitin directly to but elongates monoubiquitinated substrate protein. Mediates the selective degradation of short-lived and abnormal proteins, such as the endoplasmic reticulum-associated degradation (ERAD) of misfolded lumenal proteins. Ubiquitinates huntingtin. May mediate foam cell formation by the suppression of apoptosis of lipid-bearing macrophages through ubiquitination and subsequence degradation of p53/TP53. Proposed to be involved in ubiquitination and proteolytic processing of NF-kappa-B; in vitro supports ubiquitination of NFKB1. In case of infection by cytomegaloviruses may be involved in the US11-dependent degradation of MHC class I heavy chains following their export from the ER to the cytosol. In case of viral infections may be involved in the HPV E7 protein- dependent degradation of RB1.
|
||
Summary |
The covalent attachment of ubiquitin to cellular proteins is catalyzed by members of a family of ubiquitin-conjugating enzymes, including UBC1 (E2). These enzymes participate in a variety of cellular processes, including selective protein degradation, DNA repair, cell cycle control, and sporulation (1). In this mechanism, the ATP-coupled activation and subsequent ligation of ubiquitin are catalyzed by separate enzymes (E1 and E3, respectively) functionally linked by ubiquitin carrier protein UBC1 (E2). Carrier protein has been proposed to constitute a family of isozymes having molecular masses of 14, 17, 20, 24, and 32 kDa whose role is to shuttle activated polypeptide in the form of a high-energy thiol ester intermediate to the carboxyl terminus of ubiquitin (2). The order of ubiquitin transfer is from E1 to E2, from E2 to E6-AP, and finally from E6-AP to a substrate (3).
|
||
Form |
50 mM Tris-Glycine (pH 7.4), 0.15 M NaCl, 40% Glycerol, 0.01% sodium azide and 0.05% BSA. |
||
Storage & Stability |
Store at +4°C short term. For long-term storage, aliquot and store at -20°C or below. Stable for 12 months at -20°C. Avoid repeated freeze-thaw cycles.
|
||
Applications |
WB, IHC
|
||
Dilution |
WB~~1:1000~10000
IHC~~1:250~500
|
||
Synonyms |
Ubiquitin-conjugating enzyme E2 K, Huntingtin-interacting protein 2, HIP-2, Ubiquitin carrier protein, Ubiquitin-conjugating enzyme E2-25 kDa, Ubiquitin-conjugating enzyme E2(25K), Ubiquitin-conjugating enzyme E2-25K, Ubiquitin-protein ligase, UBE2K, HIP2, LIG
|
||
Images |

A. Western blot analysis on Daudi cell lysate using anti-UBC1 RabMAb (Cat. APR13898G), dilution 1:100,000.
B. Immunohistochemical staining of paraffin-embedded human liver using anti-UBC1 RabMAb (Cat. APR13898G). |
||
Specification |
|||
Quantity |
|
||
| Select | Brand | Catalog No. | Product Name | Pack Size | Type | Field of Research | Specification | Quantity | Price(USD) | |
| 1 | Leading Biology | APG02467G | CCK4 / PTK7 Antibody (clone 4F9) | 50 μl | Monoclonal Antibodies |
|
$495.00 | Add Ask | ||
| 2 | Leading Biology | AMM04683G | GALT Antibody (clone 4C11) | 50 μg | Monoclonal Antibodies |
|
$545.00 | Add Ask | ||
| 3 | Leading Biology | AMM01402G | Vimentin (Mesenchymal Cell Marker) Antibody - With BSA and Azide | 50 ug | Monoclonal Antibodies |
|
$395.00 | Add Ask | ||
| 4 | Leading Biology | APR08280G | LTA4H / LTA4 Antibody (clone 9G8) | 50 μl | Monoclonal Antibodies |
|
$495.00 | Add Ask | ||
| 5 | Leading Biology | AMM00172G | CD1a / HTA1 (Mature Langerhans Cells Marker) Antibody - With BSA and Azide | 50 ug | Monoclonal Antibodies |
|
$395.00 | Add Ask | ||
| 6 | Leading Biology | AMM05750G | CEBPA Antibody | 100 μl | Monoclonal Antibodies |
|
$545.00 | Add Ask |
 Leading Biology Inc.
2600 Hilltop DR, Building G, B Suite C138
Richmond, CA, 94806
Tel: 1-661-524(LBI)-0262
Email: info@leadingbiology.com
Leading Biology Inc.
2600 Hilltop DR, Building G, B Suite C138
Richmond, CA, 94806
Tel: 1-661-524(LBI)-0262
Email: info@leadingbiology.com
Complete this form and click send to ask us a question, request a quote or simply say hello.

You have 0 item in your cart

You have 0 item in your inquiry list
